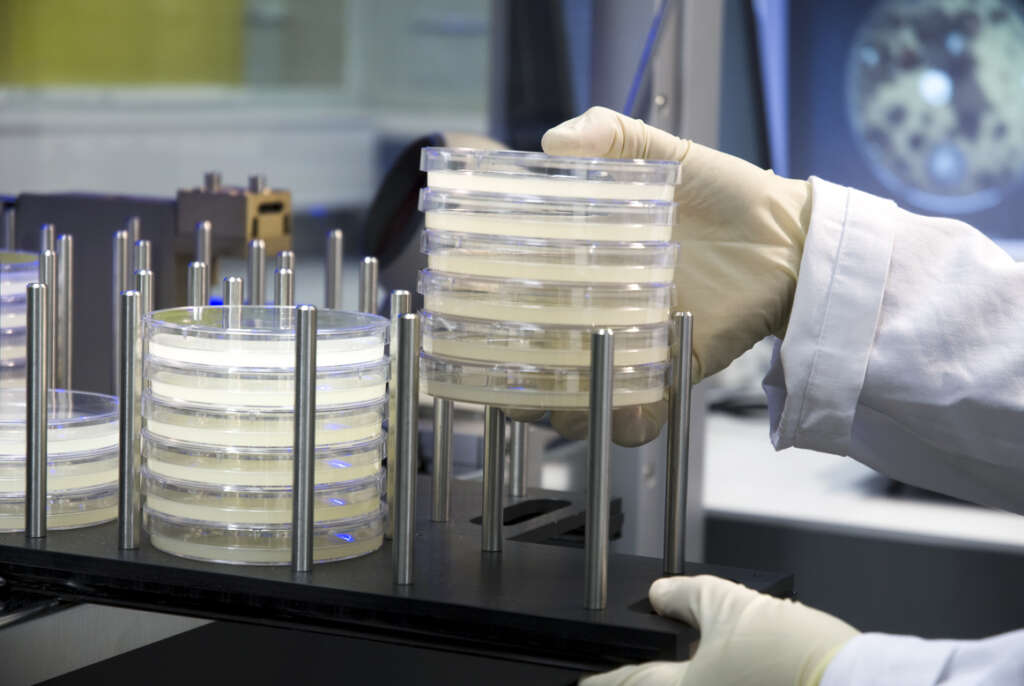

Pharma Mar: así son las expediciones submarinas que descubrieron el Aplidin
Los buzos de Pharma Mar se sumergen en busca de invertebrados marinos con moléculas con capacidad antitumoral mediante un complejo proceso que llena los almacenes de la farmacéutica con más de 250.000 muestras
Los buceadores de Pharma Mar en una expedición marina. / Cedida Pharma Mar
Pharma Mar lleva desde mediados de los ochenta sumergida en la lucha contra el cáncer. Hace 35 años que la farmacéutica de origen gallego investiga mares y océanos en busca de moléculas con capacidad antitumoral, valiéndose de equipos de buzos profesionales que operan en todo el mundo. Este método ha servido para dar a luz a fármacos como Aplidin o Yondelis pero, ¿cómo son estas expediciones submarinas?
«La mayoría de los fármacos que se conocen hasta el momento son de origen natural, ¿qué hacemos buscando en la tierra, si el 80% de la biodiversidad está en el fondo marino?«, fue la pregunta que dio origen a Pharma Mar en 1986. Según explican desde la multinacional a Economía Digital Galicia, en aquel momento «nadie hacía esa búsqueda de manera sistemática», componiendo la excusa perfecta para el nacimiento de esta subsidiaria de la viguesa Zeltia.
¿Qué buscan los buzos, y dónde?
En las expediciones submarinas, los buceadores buscan invertebrados «en un proceso totalmente manual y selectivo llevado a cabo por un equipo de buzos profesionales y biólogos marinos». Las muestras que se toman son siempre cantidades mínimas, de aproximadamente dos gramos, lo suficiente para averiguar «si tienen capacidad antitumoral». Una vez extraído el material, se embolsa y se sube al barco inmediatamente, donde se congela a -30 grados y se envía a la sede que la farmacéutica tiene en Colmenar Viejo (Madrid).
Pharma Mar ha llevado a cabo estas expediciones por todo el mundo. En circunstancias normales, antes de la pandemia de Covid-19, se autorizaban entre 6 y 8 al año. El proceso suele tener una duración de un mes y se hace en lugares donde haya «la mayor biodiversidad posible, sobre todo en zonas cálidas, pero también se ha hecho alguna en la Antártida». Ahora mismo no hay ninguna expedición en Galicia, ni la habrá en un futuro próximo, aunque sí se han realizado varias en la zona a lo largo de la historia.
Del mar al blíster
En los almacenes de Pharma Mar hay ahora mismo más de 250.000 muestras marinas, según asegura la compañía. Pero, ¿cómo se convierte este material en un medicamento? Lo cierto es que las muestras no se utilizan para el proceso de fabricación de los fármacos, solo para investigación. El procedimiento es el siguiente: los científicos descongelan lo recolectado por los buzos, lo desfragmentan y comprueban si tiene capacidades antitumorales mediante un cribado con placas con diferentes tipos de células tumorales. Si mata o inhibe a estas células, es que funciona.
Aquellas muestras que pasan esta prueba se someten a otra desfragmentación hasta encontrar la perla por la que se hace todo este proceso: la molécula con capacidad anticancerígena. «Nuestros científicos tienen que ser capaces de reproducir la molécula de manera idéntica a la que ha creado la naturaleza, y la replicamos de manera sintética. Se hace así por las necesidades regulatorias del fármaco, por la imposibilidad de hacer macroplantaciones y porque eso no es viable ni ético ecológicamente hablando», señalan desde Pharma Mar.
Después de esto se hacen los ensayos preclínicos, que se pueden hacer en vivo (en animales) o en vitro (en placas). Si eso sale bien, acorde a las autoridades reguladoras (FDA, EMA…) viene la fase clínica, que tiene tres etapas, con ensayos en humanos. En la primera fase se busca la dosis adecuada, en la segunda se testea la eficacia del producto, y en la tercera y última se compara con el estándar de tratamiento en el mercado.
Así se fabrica el Aplidin
Hasta no hace mucho, Pharma Mar orientaba su trabajo exclusivamente hacia la oncología, pero con la irrupción del Covid comenzaron a explorar tratamientos antivirales, haciendo realidad el Aplidin (plitidepsina). El antitumoral concluirá este mes de noviembre su ensayo clínico de fase III en Brasil, según revela un documento de la Agência Nacional de Vigilância Sanitária. Actualmente, el medicamento contra el coronavirus se prueba en casi una veintena de hospitales españoles.
La farmacéutica encontró la ascidia (una clase de pequeños invertebrados marinos) Aplidium albicans en las aguas de Ibiza, concretamente en la isla de Es Vedrà, según señala la compañía. El organismo vive a -30 metros de profundidad y se desarrolla en primavera. Una vez extraído, se siguió el proceso explicado anteriormente, aislando la molécula con capacidad curativa, y se creó el antitumoral que ahora se reconvertirá a antiviral.
Compartían buques con Pescanova
La logística de extracción de muestras tiene una parte muy complicada, que es la congelación del material, muy susceptible a problemas con la cadena de frío. A mediados de los ochenta, Manuel Fernández de Sousa-Faro, el ahora expresidente de Pescanova, dejaba subir a sus buques a los equipos de buceo de la farmacéutica que dirige su hermano José María. Desde Pharma Mar remarcan que aquello fue «algo muy anecdótico, que pasó en una fase muy inicial», ya que ahora ese tipo de colaboraciones las hacen «con universidades, centros de investigación, los propios países… todo regulado por el protocolo de Kioto y el protocolo de Nagoya, con personas muy profesionales».
Y es que el imperio de José María Fernández de Sousa-Faro ha crecido como la espuma, todo gracias a estas expediciones marinas. El océano guarda muchos secretos y todavía queda mucho por explorar. «Hasta hemos descubierto especies nuevas a las que hemos nombrado nosotros y todo», presumen desde la farmacéutica.